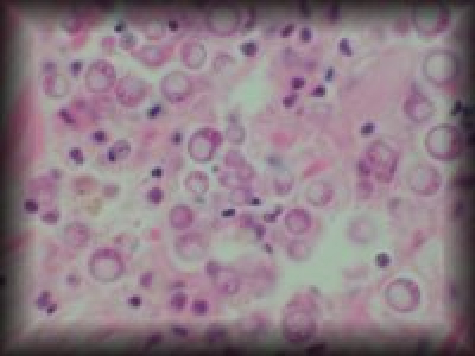
Perkinsus andrewsi
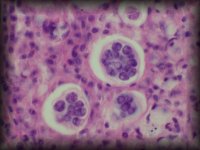
P. chesapeaki

Haplosporidium nelsoni plasmodia in Crassostrea virginica |
 Haplosporidium nelsoni spores in C. virginica |
 Haplosporidium nelsoni spores in C. virginica |
 Haplosporidium nelsoni plasmodia in C. virginica (plastic section) |
 Haplosporidium nelsoni plasmodia in C. virginica |
 Haplosporidium nelsoni spores C. virginica |
 Haplosporidium costale spores in C. virginica |
 Haplosporidium costale prespores in C. virginica |
 Haplosporidium costale spores in C. virginica |
Perkinsus andrewsi in Macoma balthica |
 Perkinsus chesapeaki in mya arenaria |
Perkinsus chesapeaki in Mya arenaria |
 Perkinsus marinus in C. virginica |
 Perkinsus marinus in C. virginica |
 Perkinsus marinus in C. virginica |
 Perkinsus marinus in C. virginica |
 Perkinsus marinus in C. virginica |
 QPX in mercenaria mercenaria |
|
 QPX in Mercenaria mercenaria |
|